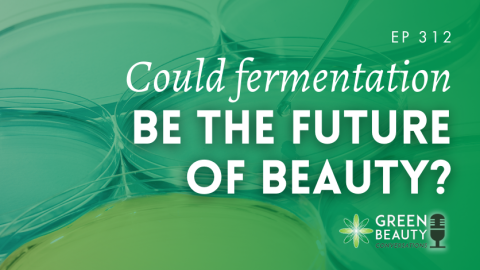

Could fermentation shape the future of beauty? Discover how microbes, biotech oils and ancient fermentation processes could challenge beauty’s...
Archive for category: Podcast
Discover how fermentation-derived oils could replace palm oil in cosmetics in this episode of Green Beauty Conversations featuring ÄIO...
Are beauty brand founders sabotaging their success by hiding behind screens? Discover how meeting customers face-to-face could transform your...
Discover what it really takes to start a beauty brand with your family in this episode of Green Beauty...
Podcast 308: The woman who invented the modern beauty industry (and you’ve never heard her name)
, PodcastDiscover how one single woman invented the modern beauty industry, and how her marketing genius continues to influence beauty...
Think you need to be a chemist to formulate? Think again. In this episode of Green Beauty Conversations, Lorraine...
How did eye makeup become an everyday expectation? Discover how 5,000 years of history shaped today’s eye makeup habits...
We brush our teeth twice a day without even thinking, yet most of us can’t name a single thing...
What really defines indie beauty – and why does it so often unravel when the founder steps away? In...
Animal fats are everywhere right now – but not in the way you might expect. Beef tallow has exploded...
FREE TRAINING
Learn how to become an Organic Skincare Formulator
FREE TRAINING
How to become an Organic Skincare Entrepreneur
FREE TRAINING
How to become an Organic Skincare Entrepreneur
Our Top Posts
-
8 Points You MUST Know Before Making Homemade Skincare
-
How to Start a Cosmetic Business at Home
-
Everything you wanted to know about Organic & Natural Emulsifiers
-
16 Point Checklist: Choosing a Natural Preservative for Skincare
-
How to make a Whipped Body Butter
-
How to Make a Natural Shampoo with Mint & Rosemary